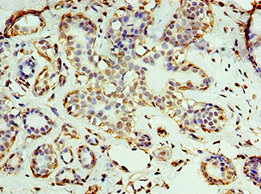

-
中文名稱:RNLS兔多克隆抗體
-
貨號:CSB-PA726123ESR1HU
-
規格:¥440
-
圖片:
-
其他:
產品詳情
-
產品名稱:Rabbit anti-Homo sapiens (Human) RNLS Polyclonal antibody
-
Uniprot No.:
-
基因名:
-
別名:6530404N21Rik antibody; AI452315 antibody; AW060440 antibody; C10orf59 antibody; Chromosome 10 open reading frame 59 antibody; FLJ11218 antibody; HGNC:25641 antibody; Hypothetical protein LOC55328 antibody; MAO C antibody; MAO-C antibody; mMAO C antibody; Monoamine oxidase C antibody; Monoamine oxidase-C antibody; Renalase antibody; Renalase FAD dependent amine oxidase antibody; RNLS antibody; RNLS_HUMAN antibody
-
宿主:Rabbit
-
反應種屬:Human
-
免疫原:Recombinant Human Renalase protein (18-342AA)
-
免疫原種屬:Homo sapiens (Human)
-
標記方式:Non-conjugated
-
克隆類型:Polyclonal
-
抗體亞型:IgG
-
純化方式:Antigen Affinity Purified
-
濃度:It differs from different batches. Please contact us to confirm it.
-
保存緩沖液:PBS with 0.02% sodium azide, 50% glycerol, pH7.3.
-
產品提供形式:Liquid
-
應用范圍:ELISA, IHC
-
推薦稀釋比:
Application Recommended Dilution IHC 1:20-1:200 -
Protocols:
-
儲存條件:Upon receipt, store at -20°C or -80°C. Avoid repeated freeze.
-
貨期:Basically, we can dispatch the products out in 1-3 working days after receiving your orders. Delivery time maybe differs from different purchasing way or location, please kindly consult your local distributors for specific delivery time.
-
用途:For Research Use Only. Not for use in diagnostic or therapeutic procedures.
相關產品
靶點詳情
-
功能:Catalyzes the oxidation of the less abundant 1,2-dihydro-beta-NAD(P) and 1,6-dihydro-beta-NAD(P) to form beta-NAD(P)(+). The enzyme hormone is secreted by the kidney, and circulates in blood and modulates cardiac function and systemic blood pressure. Lowers blood pressure in vivo by decreasing cardiac contractility and heart rate and preventing a compensatory increase in peripheral vascular tone, suggesting a causal link to the increased plasma catecholamine and heightened cardiovascular risk. High concentrations of catecholamines activate plasma renalase and promotes its secretion and synthesis.
-
基因功能參考文獻:
- Data (including data from studies in knockout mice) suggest that renalase functions as a protective plasma protein that reduces pancreatic acinar cell injury and prevents pancreatitis via interactions with plasma membrane calcium ATPase PMCA4b. PMID: 29042438
- renalase may reduce renal tubular injury and apoptosis of renal tubular epithelial cells. PMID: 30074185
- Urinary renalase concentration is reduced in the aftermath of coronary angiography/percutaneous coronary intervention, which may be related to contrast induced-acute kidney injury development. PMID: 27778420
- we focus on the cytoprotective actions of renalase and its capacity to sustain cancer cell growth and also the translational opportunities these findings represent for the development of novel therapeutic strategies for organ injury and cancer PMID: 28238213
- There is a high level of circulating renalase and advanced oxidation protein products in the heamodialysis patients. PMID: 28954489
- Rs10887800 polymorphic variant of RNLS gene influences the level of circulating RNLS in patients undergoing hemodialysis, but not in healthy controls. PMID: 28372594
- data suggest that renalase might play a role in hypertrophic response to pressure overload, but the exact mechanism requires further investigation PMID: 29065134
- The development of preeclampsia in pregnant is accompanied by altered serum renalase levels. PMID: 27147460
- High RNLS expression is associated with melanoma. PMID: 27197188
- Renalase gene rs2296545 polymorphism is significantly associated with increased risk of hypertension(HT), whereas rs2576178 polymorphism may not be associated with the susceptibility to HT PMID: 27434211
- The rs10887800 renalase gene polymorphism significantly increased the risk of coronary artery disease in hemodialyzed end-stage renal disease patients. PMID: 27023477
- genetic association studies in a population of pregnant women in Pakistan: Data suggest that an SNP in renalase (rs10887800; but not rs2576178) is modestly associated with gestational diabetes mellitus in the population studied; no difference was observed in the serum levels of renalase in this case-control study. PMID: 27507673
- analysis of metabolic function of renalase PMID: 27769837
- Lack of the N-terminal peptide, the structural precondition for FAD binding, suggests that extracellular (circulating) renalase acts in a FAD-independent manner and mechanisms of its action are not associated with FAD. PMID: 27577995
- Findings of the present study suggest that blood pressure may be increased by GG genotype and G allele of rs10887800 renalase polymorphism and the polymorphism may increase the susceptibility to preeclampsia. PMID: 27155338
- plasma renalase was not significantly associated with hypertension and high brachial-ankle pulse wave velocity PMID: 27871085
- Data show that nhibition of renalase caused tumor cell apoptosis and cell cycle arrest. PMID: 26972355
- marked increase of glomerular renalase and its association with macrophages suggest that it might play an important role in disease progression of LN PMID: 26431044
- Studies indicate definitive links between renalase catecholamine consumption and physiological responses. PMID: 25900362
- the antihypertensive effect of renalase still remains a phenomenon with unclear biochemical mechanim(s) and functions of intracellular and extracellular (circulating) renalases obviously differ. PMID: 26716738
- Single nucleotide polymorphisms in nNOS, renalase, MTHFR, CELSR1 and XYLB genes were found significantly associated with ischemic stroke in Chinese patients. PMID: 25855559
- Serum levels of renalase are highly correlated with catecholamine and both serum renalase levels and renalase-catecholamine ratios are related to renal function PMID: 24590362
- An association has been found between renalase (rs2296545) CC genotype and C allele and chronic kidney disease, along with significantly high serum epinephrine level. PMID: 25484193
- Renalase levels were higher in heart transplant recipients compared with healthy volunteers. PMID: 25380930
- This article demonstrates that renalase does not catalyze the oxidation of neurotransmitter catecholamines. PMID: 26049000
- study is the first to present reference values of urine renalase excretion in a healthy pediatric population PMID: 25060760
- the metabolic function of renalase is to oxidize isomeric NAD(P)H molecules to beta-NAD(P)(+). PMID: 25531177
- Renalase gene rs2296545 polymorphism is not important factor determining renal allograft function. PMID: 24923329
- The allele A of rs2576178 may be a predisposing factor of coronary heart disease in hypertensive patients, and hypertensive patients with AA genotype are susceptible to develop coronary heart disease. PMID: 24821235
- Renalase transcript levels are associated with endogenous SP1, STAT3 and ZBP89 levels. PMID: 25295465
- Our findings show that the polymorphism rs10887800 in the renalase gene is closely associated with severe intracranial cerebral atherosclerotic vascular stenosis in ischemic stroke patients of north Chinese Han origin. PMID: 24014100
- Renalase promotes cell survival and protects against renal injury through the activation of intracellular signaling cascades, independent of its ability to metabolize catecholamines. PMID: 24511138
- Elevated level of circulating renalase in dialysis patients is related to kidney function and the sympathetic nervous system hyperactivity found in this population. PMID: 23530612
- Neither the oxidized nor the reduced form of renalase is able to catalyze anomerization, implying that the redox and anomerization chemistries are inextricably linked through a common intermediate. PMID: 24266457
- SNPs rs10887800 & rs2576178 were significantly associated with ischemic stroke with hypertension. The recessive model showed a strong association of rs2296545 with ischemic stroke patients in hypertension subgroups. PMID: 23564542
- Renalase may play a critical role in reproduction and hormone regulation. PMID: 23271136
- A significant inverse correlation exists between serum renalase and residual kidney function. PMID: 22539018
- Renalase is elevated among heart transplant recipients and is predominantly dependent on renal function PMID: 23375328
- results are the first to suggest an association between renalase gene polymorphisms analysed and hypertension in dialysed patients. PMID: 21617193
- genome-wide association studies in European ancestry groups: Data suggest that alleles conferring susceptibility to type 1 diabetes [renalase (RNLS; rs10509540) and interleukin-2 (IL-2; rs2069763)] are associated with lower age-at-diagnosis/onset). PMID: 22891215
- Both before and after adjustment for sex, age and body mass index, the renalase polymorphisms did not show any effect on hypertension prevalence. PMID: 22812913
- Studies in humans with resistant hypertension indicate that plasma renalase levels are inversely associated with systolic blood pressure--REVIEW PMID: 21424526
- polymorphisms of the renalase gene in hemodialysed patients were associated with hypertension [review] PMID: 22227817
- The renalase gene polymorphism was associated with hypertension in type 2 diabetes patients. The most interesting result was a strong association of the rs10887800 polymorphism with stroke in patients with and without diabetes. PMID: 21964580
- Renalase, highly elevated in heart transplant recipients, is predominantly dependent on kidney function, which deteriorates with time after heart transplantation and age. PMID: 22172866
- Renalase is highly elevated in kidney transplant recipients, predominantly dependent on kidney function, which deteriorates with time after kidney transplantation and age. PMID: 21996211
- Renalase adopts the p-hydroxybenzoate hydroxylase fold topology, comprising a Rossmann-fold-based flavin adenine dinucleotide (FAD)-binding domain and a putative substrate-binding domain. PMID: 21699903
- The two recombinant renalase forms displayed the same molecular properties. They bind equimolar amounts of FAD and appear to be correctly folded by various criteria. PMID: 20302943
- Our identification of renalase, a soluble monoamine oxidase in the brain, highlights the possible existence of other pathways regulating monoamine neurotransmitter levels in the CNS. PMID: 20168325
- secreted by the kidney, circulates in blood, and modulates cardiac function and systemic blood pressure PMID: 15841207
顯示更多
收起更多
-
亞細胞定位:Secreted.
-
蛋白家族:Renalase family
-
組織特異性:Secreted into the blood by the kidney. Highly expressed in the kidney, expressed at lower level in heart, skeletal muscle and small intestine. Its plasma concentration is markedly reduced in patients with end-stage renal disease, as compared with healthy
-
數據庫鏈接:
Most popular with customers
-
-
YWHAB Recombinant Monoclonal Antibody
Applications: ELISA, WB, IHC, IF, FC
Species Reactivity: Human, Mouse, Rat
-
-
-
-
-
-